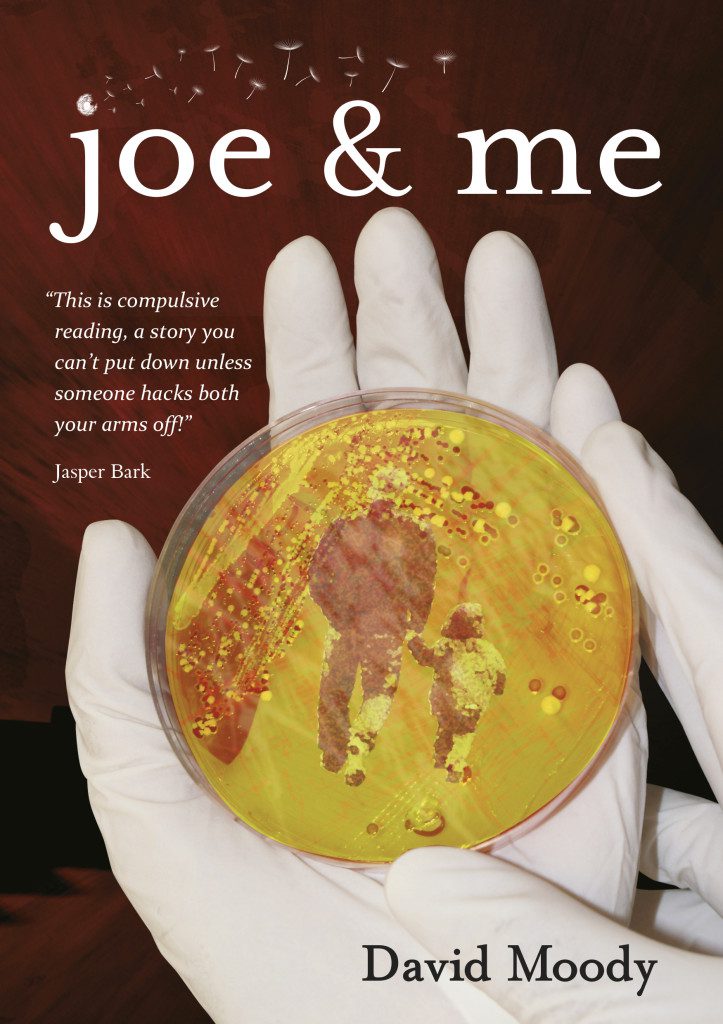
Joe and Me by David Moody audiobook

In this podcast This Is Horror and Infected Books proudly present Joe & Me written and narrated by David Moody.
Joe & Me Synopsis
Joe is anything but an ordinary eight year old. His father’s a stay-at-home Dad and his mom’s going to save the world.
Forced to live in cramped quarters after the military pull funding on his mother’s research, Joe is thrown into the midst of a race against the clock to save mankind. As tensions rise and the family disintegrates, they must face an uncomfortable ultimatum.
Do they save each other or humanity?
About David Moody
David Moody grew up on a diet of trashy horror and pulp science fiction. He worked as a bank manager before giving up the day job to write about the end of the world for a living. He has written a number of horror novels, including Autumn, which has been downloaded more than half a million times since publication in 2001 and spawned a series of sequels and a movie starring Dexter Fletcher and David Carradine. Film rights to Hater were snapped up by Guillermo del Toro (Hellboy, Pan’s Labyrinth, Pacific Rim) and Mark Johnson (Breaking Bad). Moody lives with his wife and a houseful of daughters and stepdaughters, which may explain his pre-occupation with Armageddon. Find out more about Moody at www.davidmoody.net.
Show notes
- [00:23] Joe & Me
Get involved in our live podcast with David Moody
We’re running our first ever live interview podcast with David Moody in January. This will be a very special ‘fan interaction’ podcast. This means you can send questions you want us to ask live on the podcast right now. Please send questions to Michael@thisishorror.co.uk, subject line ‘David Moody Podcast’.
Special offers
Infected Books have very kindly offered you another Christmas gift! You can make a huge saving and pick up David’s Autumn: The Human Condition (which includes Joe & Me in addition to over forty other short stories) for just £10 courtesy of the This Is Horror discount code: thisishorrorjoeandme. With an RRP of £20 this is an offer well worth taking advantage of.
Click here to purchase Autumn: The Human Condition
If you’ve yet to read Joe & Me by David Moody and want a signed physical copy to read along with the audio then you can purchase Joe & Me at the This Is Horror shop for just £1.99.
Resources
David Moody fiction (UK)
David Moody fiction (US)
Please subscribe to This Is Horror podcast RSS Feed
Listen to This Is Horror via iTunes
You can also find us on Stitcher, Zune and Blackberry.
Sponsors & Affiliates
Amazon UK
Check out some of the horror titles we think you’ll enjoy via our Amazon UK store. When you make a purchase Amazon kick-back some of the proceeds to This Is Horror which enables us to pay for the website and podcast hosting and associated costs.